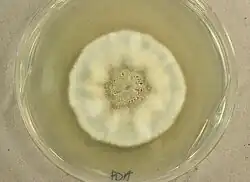

Metarhizium granulomatis
| Metarhizium granulomatis | |
|---|---|

| |
| Scientific classification | |
| Kingdom: | Fungi |
| Division: | Ascomycota |
| Class: | Sordariomycetes |
| Order: | Hypocreales |
| Family: | Clavicipitaceae |
| Genus: | Metarhizium |
| Species: | M. granulomatis
|
| Binomial name | |
| Metarhizium granulomatis (Sigler) Kepler, S.A. Rehner & Humber (2014)
| |
| Synonyms | |
| |
Metarhizium granulomatis is a fungus in the family Clavicipitaceae associated with systemic mycosis in veiled chameleons. The genus Metarhizium is known to infect arthropods, and collectively are referred to green-spored asexual pathogenic fungi. This species grows near the roots of plants and has been reported as an agent of disease in captive veiled chameleons. The etymology of the species epithet, "granulomatis" refers to the ability of the fungus to cause granulomatous disease in susceptible reptiles.[1]
History and taxonomy
Originally named Chameleomyces granulomatis, M. granulomatis resembles Paecilomyces viridis.[1] Because of the polyphyletic nature of the genus Paecilomyces Sigler and co-workers decided this species was better accommodated in a new genus in the family Clavicipitaceae.[1] The first documented case of M. granulomatis was seen in the Copenhagen Zoo, showing morphology similar to Metarhizium viride (previously called P. viridis).[1][2] This fungus causes fatal disseminated mycosis in veiled chameleons (Chamaeleo calyptratus).[2] Small subunit 18S rDNA (SSU), nuclear ribosomal internal transcribed spacer (ITS) ITS1-5.8S-ITS2, and domains D2 and D2 of the large subunit 28S rDNA (LSU) were used to demarcate the fungal species M. granulomatis and differentiate it from closely related species, particularly M. viride.[1][2][3]
Growth and morphology

Colonies of M. granulomatis differ in morphology depending on the growth medium used. Colonies on Potato dextrose agar (PDA) after 3 days incubation at 30 °C (86 °F) are white in colour and reach 3 mm in diameter.[4] Cultures developed on Sabouraud dextrose agar (SDA) are similar in appearance although they grow more slowly on this medium.[4] After 10 days, colonies on PDA reached a diameter of 27 mm and produced a diffusible brownish-grey pigment. Colonies the SDA are 12 mm in diameter and grey-ochre in colour.[4] The hyphae of M. granulomatis are septate and bear phialides that have single apical openings (monophialides) resembling a wine bottle.[1][5] The conidia produced are in short, curved, chains, appearing glassy and smooth.[1] Conidia are spherical-to-oval and 3.3-3.8 μm in length by 1.2-1.6 μm in width.[3] The fungus produces a yeast-like stage in vitro on PDA after 3 days incubation at 35°C.[1]
Pathogenicity
Metarhizium granulomatis is a rare fatal disease that infects veiled chameleons. Similar symptoms of disease are seen in M. viride.[4] Common clinical signs seen in the veiled chameleons for this fungal disease are anorexia, hemorrhages in the tongue, necrotic toes, and ulcerative skin lesions. When observing the organs commonly infected, including the visceral organs, granulomas, glossitis, pharyngitis are seen.[5] After death, cultures from the veiled lizard can be taken from the tongue, liver, lung, heart, kidney, small and large intestines.[4] 1 to 3 mm spherical yeast-like yellow-to-white nodules are visible in the lung, liver and kidney.[1]
Antifungal treatment
Treatment with nystatin and/or terbinafine may prevent further spreading or infection.[3] When isolated most isolates susceptible to terbinafine, clotrimazole, amphotericin B, voriconazole and posaconazole.[3][4] Although M. granulomatis is also resistant to some of the antifungals previously mentioned such as amphotericin B, voriconazole, fluconazole, and itraconazole.[3]
References
- ^ a b c d e f g h i Sigler, L.; Gibas, C. F. C.; Kokotovic, B.; Bertelsen, M. F. (21 July 2010). "Disseminated Mycosis in Veiled Chameleons (Chamaeleo calyptratus) Caused by Chamaeleomyces granulomatis, a New Fungus Related to Paecilomyces viridis". Journal of Clinical Microbiology. 48 (9): 3182–3192. doi:10.1128/JCM.01079-10. PMC 2937710. PMID 20660211.
- ^ a b c Schmidt, Volker; Klasen, Linus; Schneider, Juliane; Hübel, Jens; Pees, Michael; Warnock, David W. (March 2017). "Characterization of Metarhizium viride Mycosis in Veiled Chameleons (Chamaeleo calyptratus), Panther Chameleons (Furcifer pardalis), and Inland Bearded Dragons (Pogona vitticeps)". Journal of Clinical Microbiology. 55 (3): 832–843. doi:10.1128/JCM.02206-16. PMC 5328451. PMID 28003420.
- ^ a b c d e Schmidt, Volker; Klasen, Linus; Schneider, Juliane; Hübel, Jens; Pees, Michael (August 2017). "Fungal dermatitis, glossitis and disseminated visceral mycosis caused by different Metarhizium granulomatis genotypes in veiled chameleons ( Chamaeleo calyptratus ) and first isolation in healthy lizards". Veterinary Microbiology. 207: 74–82. doi:10.1016/j.vetmic.2017.06.005. PMID 28757044.
- ^ a b c d e f Schmidt, Volker; Plenz, Bastian; Pfaff, Miriam; Pees, Michael (December 2012). "Disseminated systemic mycosis in Veiled chameleons (Chamaeleo calyptratus) caused by Chamaeleomyces granulomatis". Veterinary Microbiology. 161 (1–2): 145–152. doi:10.1016/j.vetmic.2012.07.017. PMID 22857978.
- ^ a b Kepler, Ryan M.; Humber, Richard A.; Bischoff, Joseph F.; Rehner, Stephen A. (20 January 2017). "Clarification of generic and species boundaries for Metarhizium and related fungi through multigene phylogenetics". Mycologia. 106 (4): 811–829. doi:10.3852/13-319. PMID 24891418. S2CID 207683246.